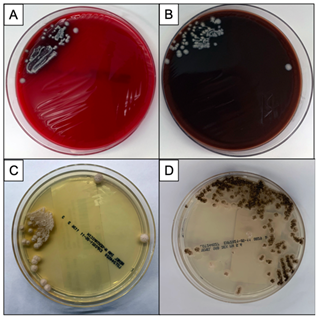

Case History
A 28 year old female presented to the emergency department (ED) with fevers, chills, and rash. A maculopapular rash began two days prior to her presentation starting at her shins, then spreading to her abdomen, chest, and arms. On presentation she had left knee and right elbow pain and had pain with walking. The patient denied neck pain, headache, blurry vision. Her past medical history is significant for bacterial meningitis between the ages of 10-12. She does not recall the causative pathogen but does recall that her mother had to quarantine for a period of time. On physical exam, the patient was in no distress, had a low-grade fever (38.2 °C) with normal heart rate and blood pressure. Her left knee and right knee were swollen, warm, and painful to the touch with limited range of motion. She was found to have round, erythematous papules and plaques, some with central purpura primarily involving both legs as well as the back and arms (Figure 1).
Initial labs showed a WBC of 11.24/L, Hgb 10.2 g/dL, platelets of 172/L. Her acute inflammatory marker was elevated (CRP 24.7 mg/dL) and her sed rate was 30 mm/hr. One of two blood cultures on admission grew Neisseria meningitides. She was initially started on vancomycin and piperacillin-tazobactam and later transitioned to ceftriaxone to complete a 7 day course. Further blood cultures remained sterile. Dermatology was consulted for her skin lesions and a biopsy of a thigh lesion revealed leukocytoclastic vasculitis. Orthopedic surgery was consulted given her left knee and right elbow swelling. X-ray revealed trace effusions in both joints. A tap of both joints was unsuccessful. The patient developed acute renal insufficiency secondary to acute tubular necrosis during her hospitalization, which improved prior to discharge. Her fevers resolved and the joint swelling and pain improved prior to discharge. She had off and on headaches during her hospitalization but denied neck pain/stiffness and never required a lumbar puncture. She was discharged on prophylactic amoxicillin.
Two months after discharge she was seen in immunology clinic at which time she was tested for humoral and complement immune deficiencies. Her total complement (CH50) was found to be low at 15 U/mL while C3 and C4 were normal, suggesting a terminal complement deficiency. Her humoral immunity panel was normal.
Discussion
Meningococcemia without meningitis occurs in 20-30% of patients with invasive meningococcal disease.1 This patient showed evidence of invasive disease with a maculopapular rash, joint involvement, and renal injury. However, her disease never reached the level of septicemia or disseminated intravascular coagulation (DIC) likely because she presented early enough in the course of her infection. A prior history of bacterial meningitidis raised suspicion for a terminal complement deficiency that was later confirmed by a low CH50. Patients with terminal compliment (C5-C9) deficiency are 1,400-10,000x more likely to develop meningococcal disease and 40-50% of these individuals can have recurrent infection.2 Deficiencies in other components of the complement pathway such as C3 and C4, especially in association with systemic lupus erythematous (SLE), and properdin (a promoter of the alternative complement pathway) can lead to invasive meningococcal disease.3 Patients with anatomic or functional asplenia and patients on eculizumab therapy are also at increased risk.4
Neisseria meningitidis is a gram negative diplococcus and is an obligate human pathogen that is also a common human commensal found in the nasopharynx of 3-25% of the population. Meningococcal disease most commonly manifests as meningitis (40-65%) and meningococcemia (20-30%) followed by pneumonia (10%), septic arthritis (2%), and chronic meningococcemia.1 The major virulence factor associated with meningococcal disease is a capsular polysaccharide, which are classified into 13 serogroups (A-L, W-135, X, Y, Z).5 Serogroups A, B, C, W-135, X, and Y are associated with invasive disease and prevalence of each serogroup is geographically varied. Diagnosis is by visualizing gram-negative diplococci on gram-stain (see Figure) from CSF or other sterile body fluid and by culture of these sterile body fluids. It is worth noting that intravenous antibiotics can sterilize meningococci in the CSF within 3-4 hours after administration.6 Transmission is by large respiratory droplets and direct contact from those with carriage or infection. Disease, especially among high-risk patients with complement deficiency, is preventable with the meningococcal conjugate vaccine. Chemoprophylaxis with rifampin, ceftriaxone, ciprofloxacin, or azithromycin is recommended for close contacts regardless of vaccination status.

References
- Stephens, D., Neisseria meningitidis. 9th ed. Principles and Practices of Infectious Diseases, ed. J. Bennett. Vol. 2. 2015.
- Ram, S., L.A. Lewis, and P.A. Rice, Infections of people with complement deficiencies and patients who have undergone splenectomy. Clin Microbiol Rev, 2010. 23(4): p. 740-80.
- Fijen CA, K.E., te Bulte MT, Daha MR, Dankert J, Assessment of complement deficiency in patients with meningococcal disease in The Netherlands. Clin Infect Dis, 1999. 28(1): p. 98-105.
- Lebel, E., et al., Post-eculizumab meningococcaemia in vaccinated patients. Clin Microbiol Infect, 2018. 24(1): p. 89-90.
- Chang, Q., Y.L. Tzeng, and D.S. Stephens, Meningococcal disease: changes in epidemiology and prevention. Clin Epidemiol, 2012. 4: p. 237-45.
- Crosswell, J.M., W.R. Nicholson, and D.R. Lennon, Rapid sterilisation of cerebrospinal fluid in meningococcal meningitis: Implications for treatment duration. J Paediatr Child Health, 2006. 42(4): p. 170-3.
-Denver Niles is the Medical Microbiology fellow at UT Southwestern Medical Center. Prior to his Medical Microbiology fellowship, he completed pediatric infectious disease training at Baylor College of Medicine/Texas Children’s Hospital.
-Dominick Cavuoti is a professor of Pathology at UT Southwestern Medical Center who specializes in Medical Microbiology, ID Pathology and Cytology.

-Clare McCormick-Baw, MD, PhD is an Assistant Professor of Clinical Microbiology at UT Southwestern in Dallas, Texas. She has a passion for teaching about laboratory medicine in general and the best uses of the microbiology lab in particular.